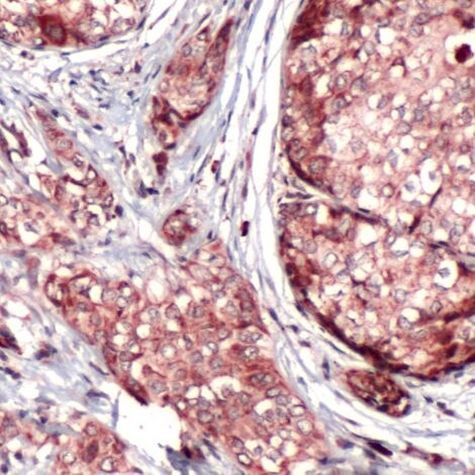
BNIP3L Antibody in Immunohistochemistry (IHC)

Search
Invitrogen
BNIP3L Polyclonal Antibody
{{$productOrderCtrl.translations['antibody.pdp.commerceCard.promotion.promotions']}}
{{$productOrderCtrl.translations['antibody.pdp.commerceCard.promotion.viewpromo']}}
{{$productOrderCtrl.translations['antibody.pdp.commerceCard.promotion.promocode']}}: {{promo.promoCode}} {{promo.promoTitle}} {{promo.promoDescription}}. {{$productOrderCtrl.translations['antibody.pdp.commerceCard.promotion.learnmore']}}
产品信息
PA5-32277
宿主/亚型
分类
类型
抗原
偶联物
形式
保存条件
运输条件
RRID
产品详细信息
Heat-mediated antigen retrieval is recommended prior to staining, using a 10mM citrate buffer, pH 6.0, for 10 minutes followed by cooling at room temperature for 20 min. Following antigen retrieval, incubate samples with primary antibody for 30 min at room temperature. A suggested positive control is breast carcinoma.
靶标信息
This gene encodes a protein that interacts with the small GTPase rab11. A similar protein in rat binds the GTP-containing active form of rab11. This protein may play a role in endosome recycling. Alternate splicing results in multiple transcript variants.
仅用于科研。不用于诊断过程。未经明确授权不得转售。